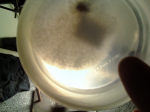

The first time I made potato-dextrose agar, It turned out to be a total mess. The main reason being is that after I had boiled either cut, sliced or grated potatoes in water for 30 minutes - it produced a very cloudy solution suspended with tons of small starchy molecules that did not really did not fall out of this semi-goopy liquid.
After reading this from sciencemadness...
I thought that it would probably also work with freezing water pushing the soluble and insoluble impurities out of the forming ice crystals. Than later when dissolved, the smaller starch particles will fall to the bottom and allow for the soluble items, such as the nutrients, and minerals to go or stay in solution.
***This would also work very well for other things I assume, such anything that can freeze and has particles suspended in it -- likely water based plant extractions would help kick out all of the tannins, etc. I could be wrong, however.
The PDA made out of this solution grows bacteria, mycelium, and whatever else that grows on PDA just as well as the not-so clear stuff. However, you can see and spot contamination, the structure of the growing organisms and droplets of water. So this makes doing various projects a lot easier.
This works really well - however pouring the clear solution off of the light particulate matter was really difficult since it just loved getting kicked back up into solution and messing everything up again. so I came up with this trick to fix that problem.
Here are some really crappy pictures to show the process I used to over come this problem. Leaving the solution in a pop bottle than poking a small hole in the side just a centimeter or so above the potato-junk layer allows for it to slowly drain off and not kick up any particulates. I used a jar and a ring stand and a clamp to set it up. Pretty simple and easy -- almost pointless pictures since its easy to understand and they really are only good as thumbnails and not as the fully expanded version.
After reading this from sciencemadness...
Quote
I did a funny little experiment with p-dichlorobenzene. I took approximately 2 grams of the solid and put this in a test tube. I heated this material, such that it became a colorless mobile liquid (I didn't measure the temperature, but it was not really hot, at most 75 C or so). To this liquid I added a tiny speck of solid iodine. This dissolves with a beautiful purple color. Next, I let the liquid cool down slowly. At a certain point in time, it solidifies, but when this happens a peculiar effect can be observed. The liquid first solidifies at the glass walls (which is expected, heat is lost through the glass walls of the test tube), but the solidified material is colorless! Slowly the solidification goes more inwards and the colorless layer reaches a thickness of well over 3 mm. Finally, when all of the material has solidified, a dark core is in the middle of the sample and a colorless/transparent layer is around the core.
So, two remarkable effects can be observed:
1) The freezing process removes the impurity of the iodine to quite a large extent.
2) The color of the dissolved iodine changes from purple to brown when the liquid solidifies.
I thought that it would probably also work with freezing water pushing the soluble and insoluble impurities out of the forming ice crystals. Than later when dissolved, the smaller starch particles will fall to the bottom and allow for the soluble items, such as the nutrients, and minerals to go or stay in solution.
***This would also work very well for other things I assume, such anything that can freeze and has particles suspended in it -- likely water based plant extractions would help kick out all of the tannins, etc. I could be wrong, however.
The PDA made out of this solution grows bacteria, mycelium, and whatever else that grows on PDA just as well as the not-so clear stuff. However, you can see and spot contamination, the structure of the growing organisms and droplets of water. So this makes doing various projects a lot easier.
This works really well - however pouring the clear solution off of the light particulate matter was really difficult since it just loved getting kicked back up into solution and messing everything up again. so I came up with this trick to fix that problem.
Here are some really crappy pictures to show the process I used to over come this problem. Leaving the solution in a pop bottle than poking a small hole in the side just a centimeter or so above the potato-junk layer allows for it to slowly drain off and not kick up any particulates. I used a jar and a ring stand and a clamp to set it up. Pretty simple and easy -- almost pointless pictures since its easy to understand and they really are only good as thumbnails and not as the fully expanded version.